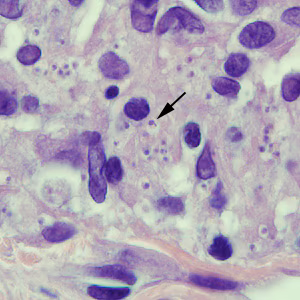

Case #250 – April, 2009
A 45-year-old man developed a few ulcerative lesions on his left forearm about one month after returning from a nature excursion in Costa Rica. He was referred to an infectious disease specialist by his primary care provider. A biopsy was obtained from the rim of one of the lesions, and subsequently sectioned and stained with hematoxylin and eosin (H&E). Figures A and B show what was observed on one of the slides. What is your diagnosis? Based on what criteria? What other testing would you recommend?

Figure A

Figure B
Images presented in the DPDx case studies are from specimens submitted for diagnosis or archiving. On rare occasions, clinical histories given may be partly fictitious.
DPDx is an educational resource designed for health professionals and laboratory scientists. For an overview including prevention, control, and treatment visit www.cdc.gov/parasites/.